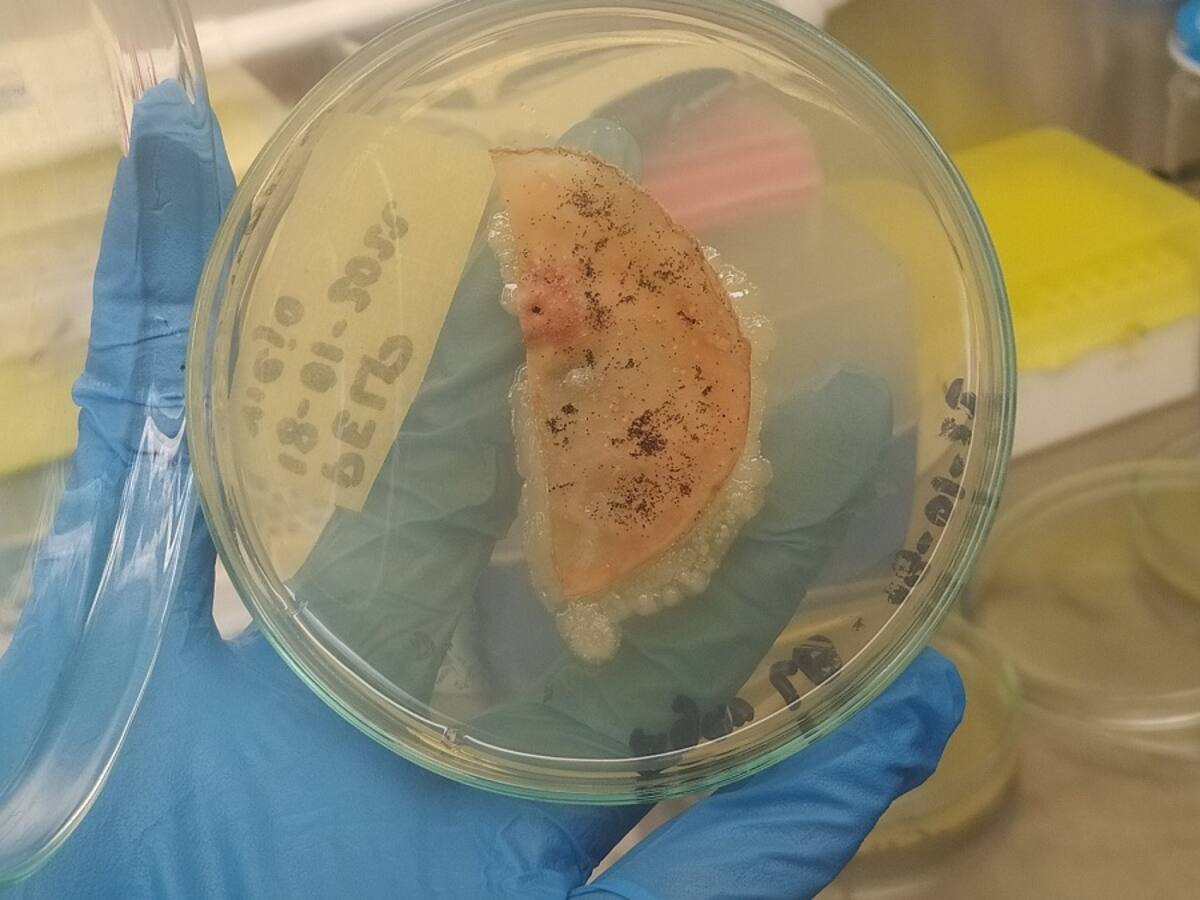
Bacterias de la Antártida podrían ayudar a eliminar residuos plásticos

Detectan misteriosas señales de radio desde el hielo de Antártida: científicos investigan su origen
Un nuevo estudio internacional pone en duda una de las hipótesis más comentadas de la física de partículas en los últimos años.
14/06/2025 - 11:45
Juan Manuel Correa

![[Audio] Anécdotas desde el buque ARC 20 de Julio en la Antártida](https://caracol.com.co/resizer/v2/RCS3GNQ5IBL3DLNSJ6CY2N2Y5Y.jpg?auth=ce245dcaf484966268aab5996973295d638581463338a02d1032ffec9defcd88&quality=70&width=1200&height=900&smart=true)













